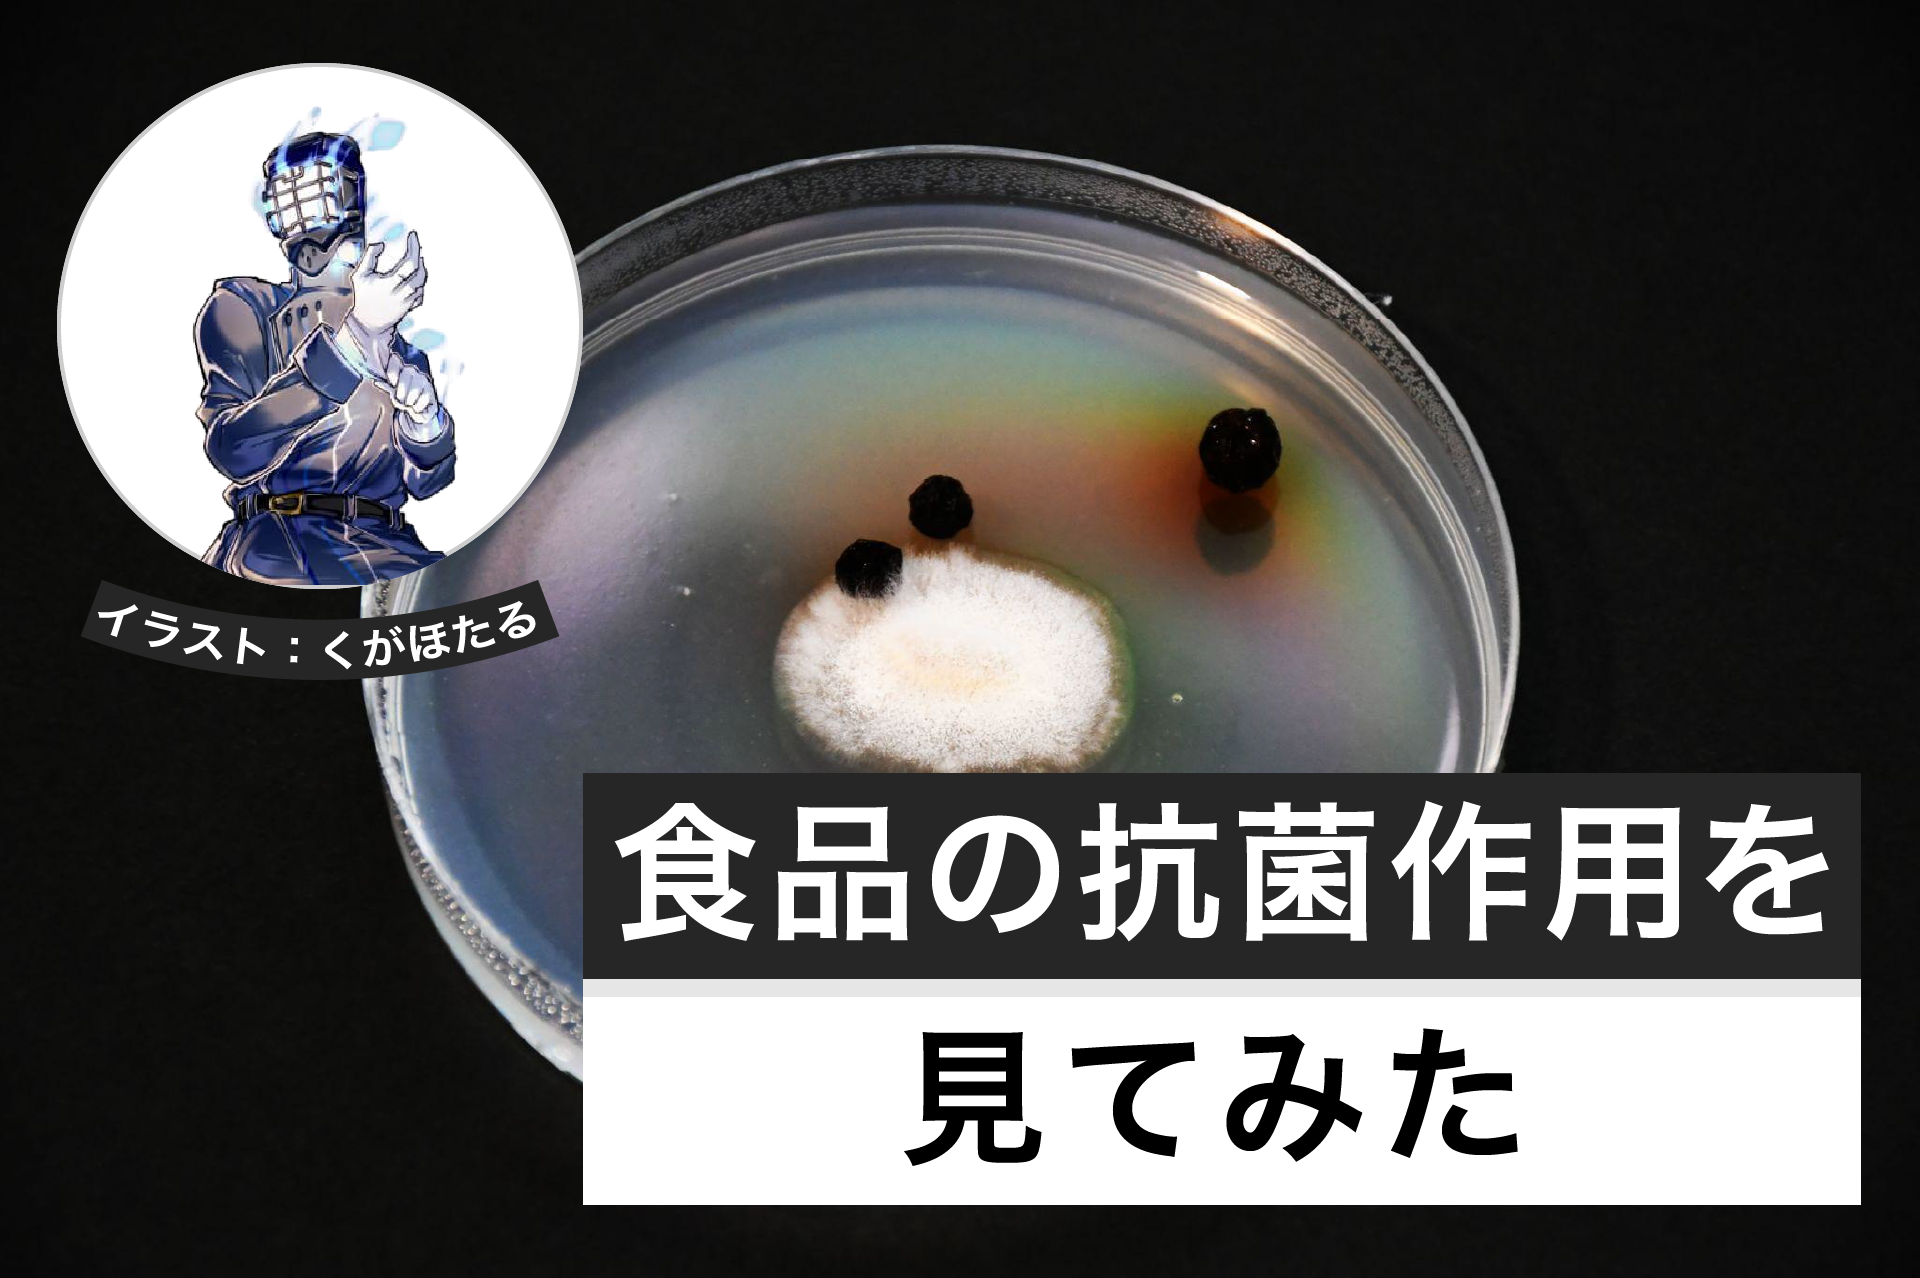

頭の体操クイズや豆知識、オモシロ実験など理系ゴコロをくすぐるエンタメ情報をお届け!

科学を愛する読者のみなさま、ごきげんよう。くられです。
使える予算は1万円以内。「高価な実験機器は使えない」という制約のなかで知恵と工夫を凝らして実行可能なおもしろ実験を紹介する本企画。第4目の今回お題はスペクトルです。
単にスペクトルというといろいろな科学の分野で使われる言葉なので、今回の実験に限って言えば正確には「輝線スペクトル」となります。難しいことはなにもなく、皆さんの知っている言葉に置き換えると「炎色反応」もっと平たく言えば、花火の色・・・となります。
花火がどうしてカラフルなのかは炎色反応によるもの(実際は炎色反応以外に燃焼温度を上げたり下げたりする補助剤によって細かな色合いが可能になっている)ということは知っている人も多いと思いますが、どうして元素によって固有の色が存在するのでしょう?
電子が飛び出した(電離した)原子や、外から過剰なエネルギーを受けた原子は、その原子の構造特有の波長の電磁波を放出します。この電磁波の波長の違いが、炎色の違いとして認識されるのです。
言い換えるとこれらの電磁波のうちたまたま人間の可視光で見分けが可能なものが炎色反応として知られているということで、この炎色反応を利用した最も有名なものが「花火」であるわけです。
今回はこの炎色反応を利用した面白い実験を紹介しましょう。
●炎色反応のキャンプファイアー
材料
──────────────────────────
・各種炎色反応試薬:1,000~3,000円程度
・各種サイズ別バット:数枚セットで3,000円程度
・メタノール:1本300円程度×4
──────────────────────────
炎色反応を利用して炎の色を変えてしまうこの実験。たとえ原理がわかっていても誰もが魅了されてしまうだろう、そんな幻想的な炎を作ることができます。
赤、青、黄、緑・・・このあたりは特に、普段見慣れない炎の色なので、非常に不思議な感じになりますね。赤はリチウム、黄色はナトリウム、緑は・・? ホウ素です。そして青色は銅です。銅はそのままだと青緑なのですがエネルギーを下げてやると青色になることが知られています。これらの炎色反応は必ずメタノールで行います。エタノールだと炭素の炎色反応である赤橙色の見慣れた炎になってしまい、炎色反応のスペクトルが埋もれてしまうことがあるからです。
青についてもう少し補足すると、花火などでは酸化剤をギリギリまで減らしたり炭酸水素ナトリウムを混ぜるなどして青色の閃光を作っているそうです。アルコールランプでやる場合は、全体量の10%程のクロロホルムやジクロロメタンといった難燃性の有機溶剤をアルコールに混ぜることで青色の炎を作ることができます。
この炎をトレイを分けて、一斉に着火するとかなりド派手で幻想的な風景を作ることができます。
このようにサイズの違うトレイを重ねてそれぞれに色味の異なるアルコールを入れて着火していきます。
幻想的という言葉がそのままピッタリな美しい炎を観察できます。
●ライターの炎の色を変えてみる
材料
──────────────────────────
・ポリエチレンの端材:今回は使わなくなったスポイトを切って使った(0円)
・銅粉:100円均一の銅製品をやすりでこすると作れる。
・トイレ用酸性洗剤:同じく100円均一のもので十分
・ピンセット:適当なものでいいのでこちらも100円均一のもので十分
・ターボライター:100円均一で売られているターボライター
──────────────────────────
先ほども触れたとおり銅の燃焼を調節すると青い炎が作れます。

これを少し応用することでターボライターの色味を恒久的に変えてしまうこともできるのです。
人前でライターを取り出して着火したときに炎の色が普通とは違う色だとかなり面白いので、是非ともやってみてください。
作り方は簡単。まずポリエチレンの端材を適当にこまかく刻みます。

今回は使わなくなったスポイトがあったのでこちらをポリエチレンの端材として使用
そこに銅粉をふりかけ、酸性洗剤(サンポール的な)を何滴か垂らしてはターボライターで炙る・・・という作業を繰り返します。銅粉が酸性洗剤で塩化銅になり、それが溶けたポリエチレンに混ざるように適当にこねていきます。

銅製品をニッパーで切って銅紛に

そこへ酸性洗剤を振りかけます
うまくやるとススを含んだヤニのような銅イオンをたっぷりふくんだポリエチレンの燃えかすのようなものができます。これをピンセットでつまみ、ターボライターの燃焼部に塗りつけます。
なんどかやっているうちに燃えかすが濡れ広がって、着火すると銅が放出されてそれが炎色反応を起こすので青色になります。かなり鮮烈に青くなって非常に綺麗です。
●身近に手に入る炎色反応に使える薬剤
最後にホームセンターや薬局で買える炎色反応に使える薬剤をいくつかまとめて紹介します。
ホウ酸
薬局で売られている消毒剤。ホウ素が黄緑色の炎色反応をしめすので非常にお手軽で美しいのでオススメ。ただしメタノールに溶けたホウ酸は刺激性がつよいので素手で絶対に触れないように。
硼砂
ホウ酸ナトリウム。ホウ素とナトリウムの炎色反応がみられる・・・と思いそうですが、実際は、ナトリウムの波長が圧倒で鮮烈な黄色の炎を作ることが可能。塩化ナトリウムでも黄色の炎はできるのですが、アルコールへの溶解度が最悪なので、ホウ酸ナトリウムのほうがベターなのです。
炭酸リチウム
真っ赤なリチウム。炭酸リチウムはそのままだとかなりアルコールに溶けにくい物質なので、少量の酸性洗剤に溶かして水分を蒸発させたあと、アルコールを加えると塩化リチウムになりアルコールによくとけ、綺麗な深紅の炎となります。
塩化カルシウム
タンスの除湿剤などで売られているアレ。中身を破いてそのままアルコールに溶かすだけでオレンジ色の炎色反応を観察することが可能です。
関連記事Recommend
-

漂白剤から取り出した酸素で金属を燃やしてみた│ヘルドクターくられの1万円実験室
-

光で物質を分析する -吸光光度計を自作してみよう│ヘルドクターくられの1万円実験室
-

ドライアイスの性質を調べよう│ヘルドクターくられの1万円実験室
-

密度測定をしてみよう│ヘルドクターくられの1万円実験室
-

簡単中和滴定をしてみよう│ヘルドクターくられの1万円実験室
-

白金線は不要。ニクロム線とアルコール法で多彩な炎色反応を観察してみた!
-

鉱物から銅を精錬しよう│ヘルドクターくられの1万円実験室
-

生物から絵具を作ろう│ヘルドクターくられの1万円実験室
-
食品の抗菌作用を見てみよう│ヘルドクターくられの1万円実験室
-

ルミノール反応で遊ぼう│ヘルドクターくられの1万円実験室











